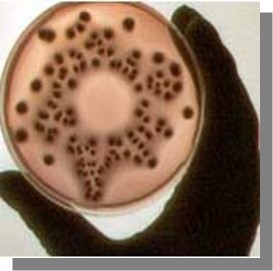
material

Стерилизация инженерных пластиков
Дата:
08.08.2012
Отрасли применения:
Широкое применение инженерных пластиков, в т.ч. и пластиков высокого уровня (PEEK, PSU и т.д.) в современной медицине выводит на первый план возможность быстрой и эффективной стерилизации как ключевого критерия для выбора материала.
Целью стерилизации является предотвращение попадания в организм болезнетворных микроорганизмов, что означает удаление или уничтожение всех живых микроорганизмов, включая такие устойчивые формы как бактерии и споры грибов.
Широко применяемый также термин дезинфекция означает низший уровень стерилизации, при котором уничтожаются болезнетворные микроорганизмы в растительном состоянии,без уничтожения спор.
Методы стерилизации
Цели стерилизации могут быть достигнуты различными методами, которые выбираются индивидуально с учетом особенностей конструктивных материалов стерилизуемых изделий. При этом, важно не какой именно метод для этого применяется, а его эффективность в конкретных условиях, т.е. снижение количества микрофлоры до приемлемого уровня.
В настоящее время для стерилизации, в т.ч. и изделий из термопластов, применяются следующие методы:
В общем, данный способ малоприменим для стерилизации изделий из пластиков (особенно многокомпонентных), вследствие низкого коэффициента теплопередачи у большинства термопластов, а значит трудностей обеспечением необходимой степени прогрева всех элементов. При этом большинство термопластов деградируют при продолжительном воздействии на них сухого жара.
Автоклавирование
При автоклавировании используется насыщенный водяной пар, что позволяет снизить температуру и продолжительность процесса. Температура и продолжительность процесса могут меняться в зависимости от применяемого цикла, в среднем же температура процесса составляет 120-125° С при давлении 0.5 бар для большинства циклов автоклавирования. Любой фактор, препятствующий контакту пара с поверхностью изделия (загрязнение, неправильная упаковка изделия или неправильная загрузка автоклава) в значительной степени снижают эффективность данного процесса.
Некоторые материалы могут терять внутреннюю целостность при температуре автоклавирования, поэтому изготовленные из них изделия должны быть должным образом закреплены для предотвращения их деформации. Даже материалы с температурой размягчения значительно выше той, при которой происходит процесс автоклавирования, могут пострадать от возникающих напряжений в структуре материала. При использовании автоклавирования обязательно необходимо учитывать эффект множественности циклов автоклавирования, чтобы избежать их негативного совокупного воздействия на материал.
В целом можно сказать, что автоклавирование наиболее широко применяется в больницах для стерилизации изделий и инструментов многократного применения. При этом он относительно мало распространен на производстве изделий, по причине сложностей с автоклавированием упакованной продукции.
Облучение
Облучение широко применяется для стерилизации в медицине, и производится либо посредством гамма излучения радиоактивного изотопа кобальта (Co60) либо пучка электронов. В обоих случаях требуется применение дорогостоящего оборудования, однако высокая эффективность процесса оправдывает эти затраты.
Доза излучения в обоих случаях измеряется в Мрад, и в среднем составляет 2.5 Мрад для стерилизации чистых изделий в воздушной среде, в анаэробных же средах дозу необходимо удваивать. Необходимо обращать внимание на то, чтобы оборудование было настроено на передачу минимальной дозы радиации, т.к. реально полученная доза будет значительно выше.
Как гамма-излучение, так и пучок электронов подразумевают использование радиации и эффект их воздействия на термопласты практически одинаков. Многие виды термопластов обладают необходимой стойкостью к к дозам радиации на уровне 2.5 Мрад. В реальности же дозы, полученные при стерилизации больше этой величины, что приносит определенный ущерб характеристикам материала. Радиационный эффект обладает свойством накопления, и в изделиях, подвергающихся частому облучению общая полученная доза быстро растет. В этих случаях необходимо вести учетные записи циклов стерилизации, во избежание превышения максимально допустимой дозы. Облучение, как метод стерилизации, чрезвычайно эффективно для изделий в упаковке, в особенности – для запечатанных одноразовых изделий и инструментов, когда требуется лишь один цикл стерилизации.
Изделия, стерилизуемые посредством облучения, неизбежно подвергаются негативному воздействию радиации, и в их материале происходят изменения молекулярной структуры – расщепление молекулярной цепочки, образование боковых ответвлений и т.д. Эти изменения приводят к ухудшению механических характеристик, а именно снижению прочности на растяжение, максимального удлинения при разрыве и ударной прочности. Степень изменения механических характеристик зависит как от вида базового термопласта, так и от наличия и вида модификаторов, стабилизаторов, и т.д. Видимый эффект воздействия радиации часто выражается в изменении цвета и пожелтении материала.
Изделия, подвергнутые стерилизации посредством облучения, абсолютно безопасны, и могут использоваться сразу после окончания цикла стерилизации.
Стерилизация в газовых средах
Применяющийся для этих целей оксид этилена является сильным алкилирующим средством, токсичным, с возможным канцерогенным эффектом. При контакте с воздухом образует горючие, и даже взрывоопасные смеси.
Эффективность стерилизации в данной среде зависит от множества факторов – продолжительности, концентрации газа, температуры и относительной влажности (для эффективного уничтожения бактерий требуется смачивание). В связи с этим, в прошлом наблюдение и управление процессом стерилизации в газовых средах было затруднено, хотя параметрические методы, пришедшие на смену стандартным биологическим индикаторам, позволили во многом их упростить.
Процесс стерилизации в газовых средах состоит из следующих этапов:
- очистка стерилизационной камеры
- увлажнение
- впуск газа и поддержка давления в камере на уровне чуть ниже атмосферного для предотвращения утечек газа в атмосферу.
Спустя установленный временной интервал камера очищается от газа и наполняется стерильным воздухом.
Это достаточно сложный процесс, который требует постоянного наблюдения, требующий больших временных затрат, по сравнению со стерилизацией облучением.
Большинство термопластов не подвержены воздействию оксида этилена, однако некоторые материалы абсорбируют данный газ, поэтому изделия из них после стерилизации должны пройти специальную обработку для удаления остатков газа.
Некоторые термопласты, в частности ПЭ, проницаемы для оксида этилена, поэтому изготовленные из них оболочки позволяют проводить стерилизацию находящихся в них изделий без их распаковки. Для эффективной стерилизации данные оболочки должны быть также проницаемы для воздуха и водяного пара.
Выбор конструкционного материала и дизайна изделий
Наибольшую сложность для стерилизации изделий медицинского назначения представляет разнообразие материалов, используемых для изготовления этих изделий и наборов изделий. Даже относительно простое изделие или набор изделий могут состоять из десятка элементов – трубок, коннекторов, кранов, прокладок и т.д. При этом для их изготовления выбираются материалы исходя из множества параметров – оптической прозрачности, механической прочности, инертности в рабочих условиях и т.д. Проблема заключается в том, что различные виды термопластов ведут себя по разному при различных методах стерилизации, и зачастую производитель обнаруживает что изделие в целом не может быть эффективно стерилизовано.
В связи с этим, возможные методы стерилизации, должны обязательно учитываться при выборе материала на самых ранних стадиях проектирования изделий. Дополнительную сложность придает разнообразие версий или типов одного и того же термопласта, в частности ПВХ может быть суспензионным, эмульсионным и полимеризованным в массе, причем в тысячах разновидностей в зависимости от количества и типа используемых модификаторов, стабилизаторов, наполнителей и т.д. При этом каждая из разновидностей по разному реагирует на различные методы стерилизации, поэтому вопрос об устойчивости ПВХ к какому-либо конкретному методу стерилизации не имеет однозначного ответа.
Тем не менее, общая информация о стойкости различных видов термопластов к различным методам стерилизации может быть сведена в таблицу:

Целью стерилизации является предотвращение попадания в организм болезнетворных микроорганизмов, что означает удаление или уничтожение всех живых микроорганизмов, включая такие устойчивые формы как бактерии и споры грибов.
Широко применяемый также термин дезинфекция означает низший уровень стерилизации, при котором уничтожаются болезнетворные микроорганизмы в растительном состоянии,без уничтожения спор.
Методы стерилизации
Цели стерилизации могут быть достигнуты различными методами, которые выбираются индивидуально с учетом особенностей конструктивных материалов стерилизуемых изделий. При этом, важно не какой именно метод для этого применяется, а его эффективность в конкретных условиях, т.е. снижение количества микрофлоры до приемлемого уровня.
В настоящее время для стерилизации, в т.ч. и изделий из термопластов, применяются следующие методы:
• Сухой жар
• Автоклавирование
• Облучение: Гамма-лучи, Пучок электронов
• Стерилизация в газовых средах
В общем, данный способ малоприменим для стерилизации изделий из пластиков (особенно многокомпонентных), вследствие низкого коэффициента теплопередачи у большинства термопластов, а значит трудностей обеспечением необходимой степени прогрева всех элементов. При этом большинство термопластов деградируют при продолжительном воздействии на них сухого жара.
Автоклавирование
При автоклавировании используется насыщенный водяной пар, что позволяет снизить температуру и продолжительность процесса. Температура и продолжительность процесса могут меняться в зависимости от применяемого цикла, в среднем же температура процесса составляет 120-125° С при давлении 0.5 бар для большинства циклов автоклавирования. Любой фактор, препятствующий контакту пара с поверхностью изделия (загрязнение, неправильная упаковка изделия или неправильная загрузка автоклава) в значительной степени снижают эффективность данного процесса.
Некоторые материалы могут терять внутреннюю целостность при температуре автоклавирования, поэтому изготовленные из них изделия должны быть должным образом закреплены для предотвращения их деформации. Даже материалы с температурой размягчения значительно выше той, при которой происходит процесс автоклавирования, могут пострадать от возникающих напряжений в структуре материала. При использовании автоклавирования обязательно необходимо учитывать эффект множественности циклов автоклавирования, чтобы избежать их негативного совокупного воздействия на материал.
В целом можно сказать, что автоклавирование наиболее широко применяется в больницах для стерилизации изделий и инструментов многократного применения. При этом он относительно мало распространен на производстве изделий, по причине сложностей с автоклавированием упакованной продукции.
Облучение
Облучение широко применяется для стерилизации в медицине, и производится либо посредством гамма излучения радиоактивного изотопа кобальта (Co60) либо пучка электронов. В обоих случаях требуется применение дорогостоящего оборудования, однако высокая эффективность процесса оправдывает эти затраты.
Доза излучения в обоих случаях измеряется в Мрад, и в среднем составляет 2.5 Мрад для стерилизации чистых изделий в воздушной среде, в анаэробных же средах дозу необходимо удваивать. Необходимо обращать внимание на то, чтобы оборудование было настроено на передачу минимальной дозы радиации, т.к. реально полученная доза будет значительно выше.
Как гамма-излучение, так и пучок электронов подразумевают использование радиации и эффект их воздействия на термопласты практически одинаков. Многие виды термопластов обладают необходимой стойкостью к к дозам радиации на уровне 2.5 Мрад. В реальности же дозы, полученные при стерилизации больше этой величины, что приносит определенный ущерб характеристикам материала. Радиационный эффект обладает свойством накопления, и в изделиях, подвергающихся частому облучению общая полученная доза быстро растет. В этих случаях необходимо вести учетные записи циклов стерилизации, во избежание превышения максимально допустимой дозы. Облучение, как метод стерилизации, чрезвычайно эффективно для изделий в упаковке, в особенности – для запечатанных одноразовых изделий и инструментов, когда требуется лишь один цикл стерилизации.
Изделия, стерилизуемые посредством облучения, неизбежно подвергаются негативному воздействию радиации, и в их материале происходят изменения молекулярной структуры – расщепление молекулярной цепочки, образование боковых ответвлений и т.д. Эти изменения приводят к ухудшению механических характеристик, а именно снижению прочности на растяжение, максимального удлинения при разрыве и ударной прочности. Степень изменения механических характеристик зависит как от вида базового термопласта, так и от наличия и вида модификаторов, стабилизаторов, и т.д. Видимый эффект воздействия радиации часто выражается в изменении цвета и пожелтении материала.
Изделия, подвергнутые стерилизации посредством облучения, абсолютно безопасны, и могут использоваться сразу после окончания цикла стерилизации.
Стерилизация в газовых средах
Применяющийся для этих целей оксид этилена является сильным алкилирующим средством, токсичным, с возможным канцерогенным эффектом. При контакте с воздухом образует горючие, и даже взрывоопасные смеси.
Эффективность стерилизации в данной среде зависит от множества факторов – продолжительности, концентрации газа, температуры и относительной влажности (для эффективного уничтожения бактерий требуется смачивание). В связи с этим, в прошлом наблюдение и управление процессом стерилизации в газовых средах было затруднено, хотя параметрические методы, пришедшие на смену стандартным биологическим индикаторам, позволили во многом их упростить.
Процесс стерилизации в газовых средах состоит из следующих этапов:
- очистка стерилизационной камеры
- увлажнение
- впуск газа и поддержка давления в камере на уровне чуть ниже атмосферного для предотвращения утечек газа в атмосферу.
Спустя установленный временной интервал камера очищается от газа и наполняется стерильным воздухом.
Это достаточно сложный процесс, который требует постоянного наблюдения, требующий больших временных затрат, по сравнению со стерилизацией облучением.
Большинство термопластов не подвержены воздействию оксида этилена, однако некоторые материалы абсорбируют данный газ, поэтому изделия из них после стерилизации должны пройти специальную обработку для удаления остатков газа.
Некоторые термопласты, в частности ПЭ, проницаемы для оксида этилена, поэтому изготовленные из них оболочки позволяют проводить стерилизацию находящихся в них изделий без их распаковки. Для эффективной стерилизации данные оболочки должны быть также проницаемы для воздуха и водяного пара.
Выбор конструкционного материала и дизайна изделий
Наибольшую сложность для стерилизации изделий медицинского назначения представляет разнообразие материалов, используемых для изготовления этих изделий и наборов изделий. Даже относительно простое изделие или набор изделий могут состоять из десятка элементов – трубок, коннекторов, кранов, прокладок и т.д. При этом для их изготовления выбираются материалы исходя из множества параметров – оптической прозрачности, механической прочности, инертности в рабочих условиях и т.д. Проблема заключается в том, что различные виды термопластов ведут себя по разному при различных методах стерилизации, и зачастую производитель обнаруживает что изделие в целом не может быть эффективно стерилизовано.
В связи с этим, возможные методы стерилизации, должны обязательно учитываться при выборе материала на самых ранних стадиях проектирования изделий. Дополнительную сложность придает разнообразие версий или типов одного и того же термопласта, в частности ПВХ может быть суспензионным, эмульсионным и полимеризованным в массе, причем в тысячах разновидностей в зависимости от количества и типа используемых модификаторов, стабилизаторов, наполнителей и т.д. При этом каждая из разновидностей по разному реагирует на различные методы стерилизации, поэтому вопрос об устойчивости ПВХ к какому-либо конкретному методу стерилизации не имеет однозначного ответа.
Тем не менее, общая информация о стойкости различных видов термопластов к различным методам стерилизации может быть сведена в таблицу:

